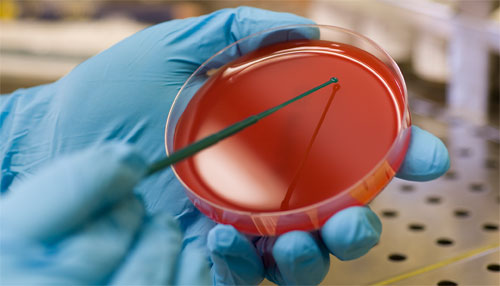

¿Necesitas la Licencia Sanitaria? Necesitas la Certificación de Manejo Seguro de Alimentos/Inocuidad de Alimentos Gerencial (ServSafe Food Safety Manager Certification, Training & Examination)el mismo día y esta es Tu oportunidad!
🔆Repaso y examen presencial. Certificado de ServSafe el mismo día*🔆
Fechas:
*Lunes 21 de octubre 2024 en Bayamón; si lo necesitas tomar antes o después e individual, en área metro favor de llamarnos (787)431-3532
*Costo $145.00pp
✳️Para fechas en Gurabo, Ponce y Mayagüez de forma grupal; favor de llamarnos para información*
787-431-3532
✳️Hablaremos de los nuevos cambios al Food Code 2017 y el Food Code 2022.

✅Información, separar espacio y para recibir materiales de estudio y repaso:
☎️(787)431-3532

🔆¡Visitamos tu Pueblo! Si no puedes asistir a nuestras fechas por la distancia, danos una llamada y con mucho gusto ofrecerle la información. Podemos visitarte de martes a sábado para que pueda tomar su examen de ServSafe (El material de estudio y repaso es enviado por correo electrónico). Al aprobar su examen (presencial en línea), recibe al momento su certificación de ServSafe con su tarjeta.
✅Incluye: Material de estudio y repaso vía correo electrónico; el día coordinado (9am-1pm) repaso y examen de ServSafe Food Safety Manager *PRESENCIAL* (el examen se ofrece en línea/online Presencial)con resultados al momento de finalizar su examen. Al aprobar su examen, obtendrá su certificado al momento, al igual que su tarjeta. Costo: $145.00pp
✴PARA SEPARAR TU ESPACIO Y RECIBIR MATERIAL DE ESTUDIO Y REPASO:
![]()
